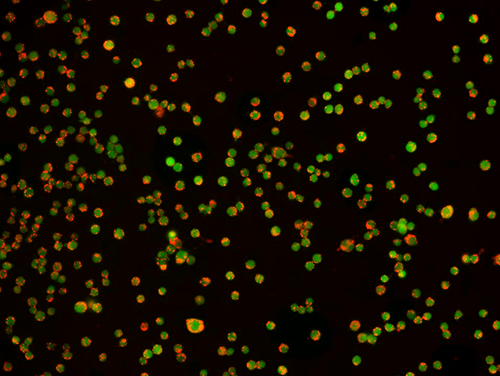
新闻图片7

公司新闻/正文
5774 人阅读发布时间:2020-09-11 14:44
细胞内pH在各种细胞事件中起重要的调节作用,包括细胞生长,钙调节,酶活性,受体介导的信号转导,离子转运,内吞作用,趋化作用,细胞粘附等等。借助pH敏感的荧光指示剂,研究人员能够以更高的灵敏度、空间分辨率、采样密度来监控活细胞内的pH波动。
通常,细胞的细胞内pH在其各个细胞区室之间会有所不同。例如,胞质溶胶的pH值介于6.8至7.4之间,而酸性细胞器(如溶酶体)的pH值介于4.5至6.0之间。因此,选择pH指示剂时,重要的是使其酸度系数(pKa)与实验系统的pH相匹配,我们提供多种荧光pH指示剂,pH指示剂葡聚糖结合物和其他试剂,用于生物系统中的pH的检测。
1. 近中性pH的检测
BCECF及其膜渗透性AM酯是用于测量细胞内pH的最广泛使用的荧光pH指示剂。它的pKa约为6.98,非常适合测量各种细胞类型的胞质中的pH变化,以及监测近中性环境中的pH变化。BCECF在〜504 nm处有一个最大吸收,在〜440 nm处有一个等吸收点,在〜527 nm处有最大发射。尽管BCECF具有双重激发的比值特性,但一些特性使比值成像不理想。其等吸收点与最大激发之间距离较大,细胞内保留性较差以及在440 nm处的弱吸收,都导致其信噪比较低。此外,BCECF以异构体的复杂混合物形式提供。
RatioWorks™BCFL,BCECF的高性能替代产品
RatioWorks™BCFL是AAT Bioquest设计的新型比值型指示剂,用于优化BCECF的不良性能和异构变异性,与BCECF相似,RatioWorks™BCFL的pKa约为7,最大吸收在503 nm处,最大发射在528 nm处。但是,RatioWorks™BCFL具有约454 nm的等吸收点,等吸收点的这个红移非常适合比值成像,因为它使RatioWorks™BCFL产生的信噪比明显高于BCECF。
RatioWorks™BCFL比值型成像技术使细胞内pH值测定基本上独立于几个可变因素,包括染料浓度,光程长度,细胞渗漏和光漂白速率。RatioWorks™BCFL可以作为不渗透膜的酸使用,也可以作为胺反应性琥珀酰亚胺酯用于标记抗体和蛋白质。
![]() |
![]() |
| BCFL激发光谱 | BCFL发射光谱 |
RatioWorks™BCFL的主要功能:
适用于细胞内pH的单波长成像和比值型成像
图1. 使用RatioWorks™BCFL,AM(Cat# 21190)和BCECF,AM(Cat# 21202)产生的标准曲线。将Hela细胞与5 µM RatioWorks™BCFL,AM在37°C下孵育30分钟。用Spexyte™ Intracellular pH Calibration Buffer Kit(Cat# 21235)中的细胞外缓冲液固定细胞内pH在4.5-8.5之间,取4个数据点的平均值,并用4参数拟合曲线,得到pH 6到8的标准曲线。
| pH 6.0 | pH 8.5 |
图2. 用RatioWorks™BCFL,AM标记的Hela细胞。将Hela细胞与5 µM RatioWorks™BCFL,AM(Cat# 21190)在37°C 下孵育30分钟。使用显微镜FITC滤光片捕获图像。将BCFL,AM溶液与Hela细胞一起温育,结果显示RatioWorks™BCFL,AM和染色的细胞质均被均匀摄取。
表1. 接近中性pH环境的比值型荧光pH探针
| 指示剂 | Ex(nm) | Em(nm) | pKa | 规格 | 货号 |
| RatioWorks™BCFL,AM | 454、503 | 528 | 〜7 | 1mg | 21190 |
| RatioWorks™BCFLAcid | 454、503 | 528 | 〜7 | 1mg | 21189 |
| RatioWorks™BCFL,SE | 454、503 | 528 | 〜7 | 1mg | 21191 |
| Cell Meter™荧光细胞内pH检测试剂盒 | 430、505 | 535 | 〜7 | 1000 Tests | 21180 |
| CytoFix™BCECF,AM *长期细胞pH示踪剂* | 440、504 | 527 | 〜6.98 | 1mg | 21202 |
| BCECF,AM | 440、504 | 527 | 〜6.98 | 1mg | 21202 |
| BCECF,AM *超纯级* | 440、504 | 527 | 〜6.98 | 20x50 µ | 21203 |
| BCECF acid * CAS#:85138-49-4 * | 440、504 | 527 | 〜6.98 | 1mg | 21201 |
2. 酸性pH检测和内吞
嗜酸探针,例如PDMPO和AAT Bioquest Protonex™染料,具有独特的特性,非常适合测量活细胞中偏酸性的细胞器的pH。作为弱碱,由于质子化这些染料能够选择性地在溶酶体和其他酸性隔室内积累。这种质子化不仅减少了背景干扰,还激活了其pH依赖性的荧光。
RatioWorks™PDMPO,双重激发|双重发射比值型pH探针
RatioWorks™PDMPO是具有酸性双激发和双发射pH探针, 它的pKa〜4.47和独特的pH依赖性荧光是测量酸性细胞器pH的理想选择。在接近中性的条件下,当以最大激发光(〜333 nm)激发时,RatioWorks™PDMPO会在〜450 nm处发出强烈的蓝色荧光。然而,在更酸性的环境中,该荧光在〜550 nm处迅速转变为深黄色。RatioWorks™PDMPO在〜386 nm处也表现出二次激发最大值。这使得能够在配备有紫色激光的流式细胞仪上进行细胞内pH测量。RatioWorks™PDMPO已成功地用作生物硅化过程中的示踪剂,并已广泛应用于二氧化硅相关研究中。
![]() |
![]() |
| PDMPO激发光谱 | PDMPO发射光谱 |
Protonex™染料,酸性pH指示剂
Protonex™Green 500和Protonex™Red 600是AAT Bioquest开发的新型pH敏感荧光染料,用于监测酸性细胞区室(例如内体和溶酶体),从而减少了信号变异性并提高了准确性。在接近中性的环境中,Protonex™染料基本上是无荧光的。直到暴露在酸性环境中,Protonex™染料的荧光强度才会增加。Protonex™Green 500的最佳激发和发射最大值分别为〜445 nm和〜503 nm,而Protonex™Red 600在〜575 nm处激发并在〜597 nm处发射。Protonex™染料可以作为胺反应性琥珀酰亚胺酯用于标记蛋白质和抗体,也可以与葡聚糖或乳胶珠偶联以研究内吞途径。
![]() |
![]() |
| Protonex™Green 500激发光谱 | Protonex™Red 600发射光谱 |
Protonex™染料的主要特点:
Protonex™Green 500和Protonex™Red 600的pKa约为6.5
图3.通过Protonex™Red 600-Latex珠缀合物(Cat# 21209)检查了RAW 264.7细胞中的吞噬作用。将RAW 264.7细胞与Protonex™600 Latex Beads在生长培养基中孵育4小时。CytoTrace™Green CMFDA(Cat# 22017)用于追踪活细胞。使用Keyence荧光显微镜拍摄图像(20X)。
表2.适用于酸性pH环境的比值型和单波长荧光pH指示剂
| 指示剂 | Ex(nm) | Em(nm) | pKa | 规格 | 货号 |
| RatioWorks™PDMPO,AM | 333 | 450、531 | 约4.47 | 1mg | 21204 |
| RatioWorks™PDMPO Dextran * 10,000 MW * | 333 | 450、531 | 约4.47 | 1mg | 21211 |
| RatioWorks™PDMPO,SE | 333 | 450、531 | 约4.47 | 1mg | 21210 |
| Protonex™Green 500 | 445 | 503 | 约6.5 | 1mg | 21215 |
| Protonex™Green 500 WS | 445 | 503 | 约6.5 | 1mg | 21218 |
| Protonex™Green 500,SE | 445 | 503 | 约6.5 | 1mg | 21216 |
| Protonex™Green 500葡聚糖 | 445 | 503 | 约6.5 | 1mg | 21217 |
| Protonex™红色600 | 575 | 597 | 约6.5 | 1mg | 21207 |
| Protonex™Red 600,SE | 575 | 597 | 约6.5 | 1mg | 21208 |
看到这儿,您心动了吗?马上联系小艾吧!
或者扫描下方二维码,即可联系您的专属客服哦~

作为一家具有高端的技术实力、先进的经营管理水平和完善的市场销售体系的生物高科技企业,总部位于武汉光谷高新技术开发区,服务面向全国。艾美捷科技是集进口试剂、实验室耗材销售、技术服务与合约开发为一体的专业化高科技公司,为用户提供专业的前沿资讯、完备的产品、整合的解决方案,及优质的物流服务。为了更好的服务客户,公司组建了一支经验丰富的研发团队-艾美捷生物技术中心,进入研发生产阶段,将更优质的产品推荐给国内生物领域的同仁们!
艾美捷科技与国内外优秀的生物试剂供应商优保持着密切的合作关系,目前已成为众多国际知名品牌的中国总代理或一级代理,主要包括:AmyJet、AAT Bioquest、Abnova、Agrisera、Biovision、Biosensis、Cayman Chemical、Caisson Labs、Cytoskeleton、CytoNiChe、Epigentek、Equitech-Bio、Hycult Biotech、Jackson、LifeSensors、LigaTrap、ProSpec、Norgen Biotek、Mabtech、Matreya、iRegene、StressMarq、ImmunoReagents、SouthernBiotech、Origene、US Biological、Solis BioDyne等,可以在短时间内为用户提供专业的前沿资讯、完备的产品及物流服务。
